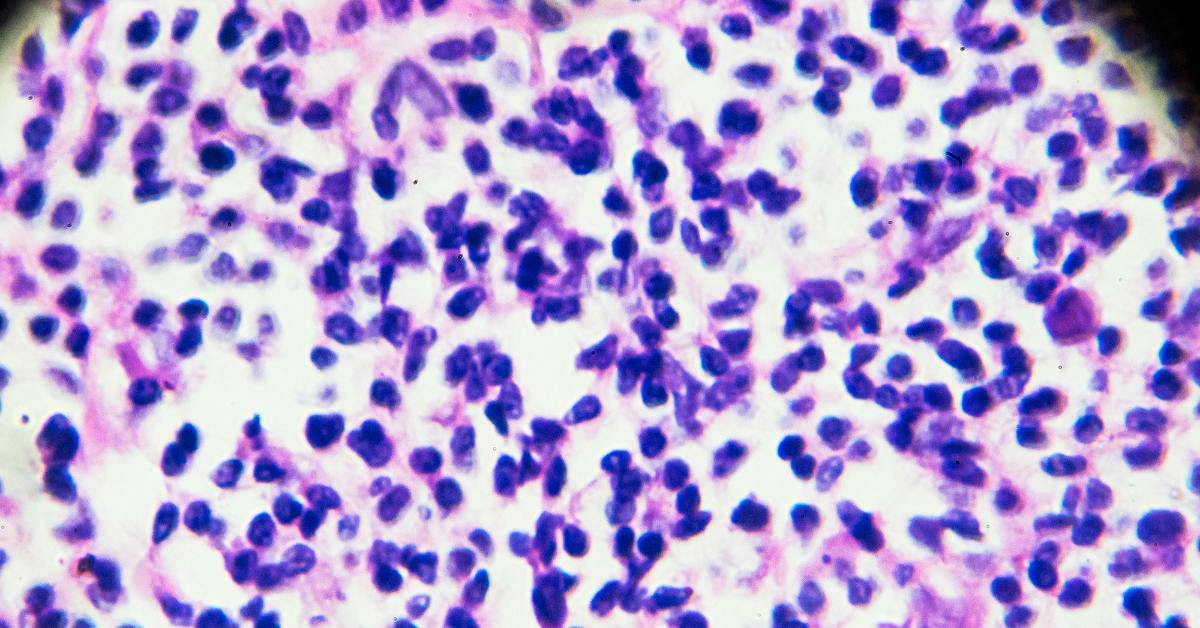

Схемы и изображения, связанные с патогенезом болезни Ходжкина

Раздел: Сокровищница опыта